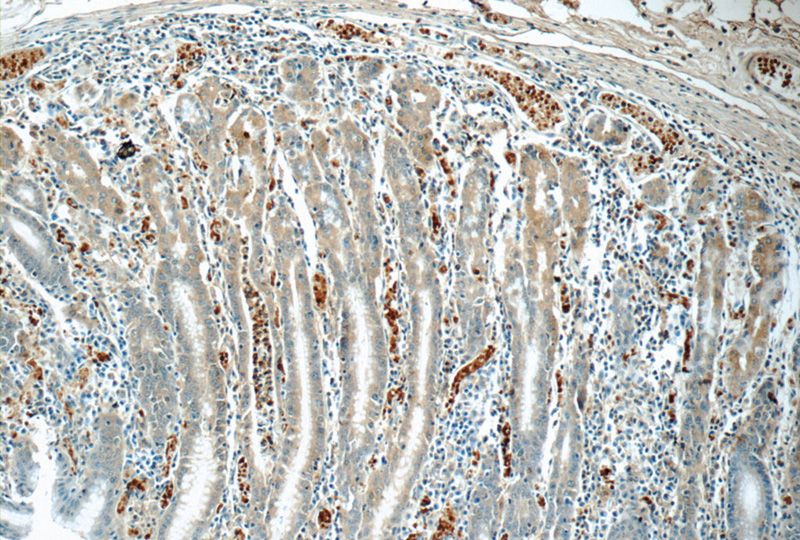
Immunohistochemistry of paraffin-embedded human stomach tissue slide using Catalog No:108147(ARL8B Antibody) at dilution of 1:50 (under 10x lens)
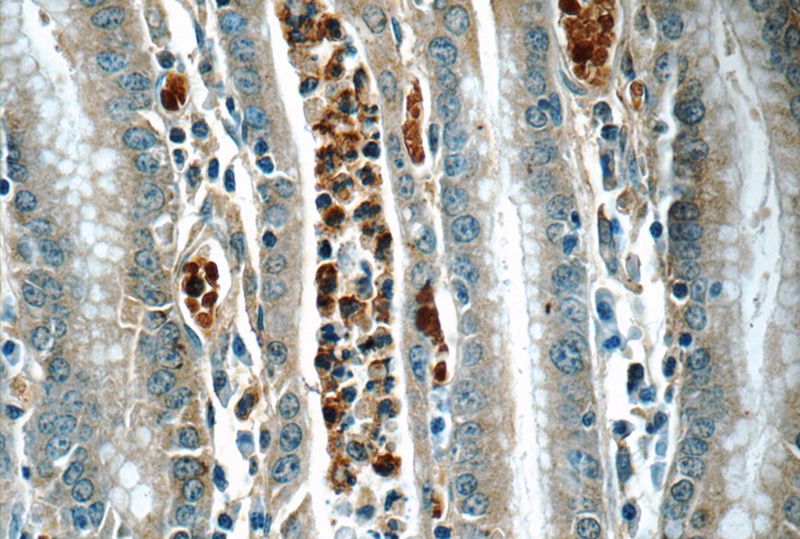
Immunohistochemistry of paraffin-embedded human stomach tissue slide using Catalog No:108147(ARL8B Antibody) at dilution of 1:50 (under 40x lens)

-
Product Name
ARL8B antibody
- Documents
-
Description
ARL8B Rabbit Polyclonal antibody. Positive WB detected in fetal human brain tissue, human brain tissue, NIH/3T3 cells. Positive IHC detected in human stomach tissue. Observed molecular weight by Western-blot: 22 kDa
-
Tested applications
ELISA, IHC, WB
-
Species reactivity
Human,Mouse,Rat; other species not tested.
-
Alternative names
ARL10C antibody; ARL8B antibody; FLJ10702 antibody; Gie1 antibody
-
Isotype
Rabbit IgG
-
Preparation
This antibody was obtained by immunization of ARL8B recombinant protein (Accession Number: NM_018184). Purification method: Antigen affinity purified.
-
Clonality
Polyclonal
-
Formulation
PBS with 0.1% sodium azide and 50% glycerol pH 7.3.
-
Storage instructions
Store at -20℃. DO NOT ALIQUOT
-
Applications
Recommended Dilution:
WB: 1:200-1:2000
IHC: 1:20-1:200
-
Validations

fetal human brain tissue were subjected to SDS PAGE followed by western blot with Catalog No:108147(ARL8B Antibody) at dilution of 1:600

NIH/3T3 cells were subjected to SDS PAGE followed by western blot with Catalog No:108147(ARL8B Antibody) at dilution of 1:1000
Immunohistochemistry of paraffin-embedded human stomach tissue slide using Catalog No:108147(ARL8B Antibody) at dilution of 1:50 (under 10x lens)
Immunohistochemistry of paraffin-embedded human stomach tissue slide using Catalog No:108147(ARL8B Antibody) at dilution of 1:50 (under 40x lens)
-
Background
ARL8B ( ADP-ribosylation factor-like 8B) , also known as ARL10C or GIE1, is a small GTPase of the Arl-family, that is associated with the lysosome. ARL8A interacts with Tubulin, and plays a role in lysosome motility, as well as in chromosomal segregation. ARL8B plays a role in the spatial distribution and positioning of lysosomes. Arl8b is regarded as a regulator of endosome to lysosome trafficking pathways of special significance for host defense.
-
References
- Korolchuk VI, Saiki S, Lichtenberg M. Lysosomal positioning coordinates cellular nutrient responses. Nature cell biology. 13(4):453-60. 2011.
- Schiefermeier N, Scheffler JM, de Araujo ME. The late endosomal p14-MP1 (LAMTOR2/3) complex regulates focal adhesion dynamics during cell migration. The Journal of cell biology. 205(4):525-40. 2014.
- Kaniuk NA, Canadien V, Bagshaw RD. Salmonella exploits Arl8B-directed kinesin activity to promote endosome tubulation and cell-to-cell transfer. Cellular microbiology. 13(11):1812-23. 2011.
Related Products / Services
Please note: All products are "FOR RESEARCH USE ONLY AND ARE NOT INTENDED FOR DIAGNOSTIC OR THERAPEUTIC USE"
